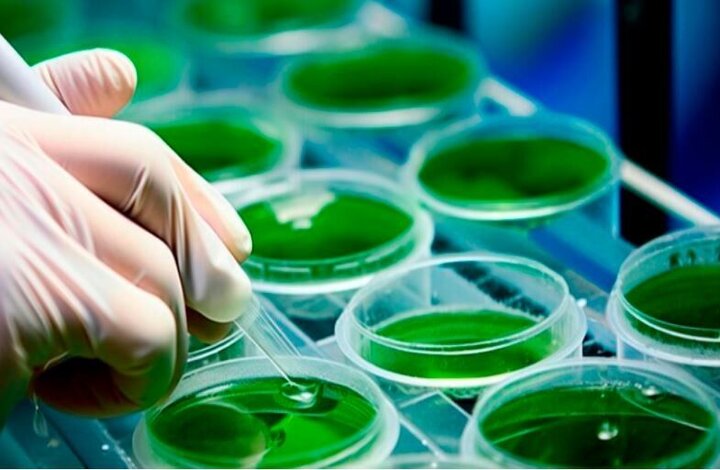
طرح فرآوری جلبک و کشاورزی دریایی هرمزگان در جمع ۵  ایده برتر کشور

به گزارش خبرگزاری ایمنا، مستوره اباذرپور با بیان اینکه ۱۲ طرح منتخب از هرمزگان از جمله طرحهای شاخص آن، فرآوری جلبک، کشاورزی دریایی، آبنبات شور، فرآوری ماهی صادراتی، طرح تولید عروسکها و نگارههای بومی خلیج فارس در همایش ملی روز روستا و عشایر ارائه شد، اظهار کرد: طرح فرآوری جلبک و کشاورزی دریایی این استان در میان پنج ایده برتر کشور قرار گرفت.
وی افزود: همچنین در بخش الگوهای مشارکتی، الگوی قشم بوم، طرح یامال و نوروز زراعی دیرستان به رئیسجمهور معرفی شد که مورد توجه ویژه قرار گرفت و بر همین اساس مقرر شد معاون توسعه روستایی رئیسجمهور، اواخر آبان سالجاری با سفر به هرمزگان، از این الگوها بهصورت میدانی بازدید کند.
مدیرکل امور روستایی و شوراهای استانداری هرمزگان گفت: معرفی طرح فرآوری جلبک و کشاورزی دریایی از استان هرمزگان بهعنوان یکی از پنج ایده برتر کشور، جلوهای از ظرفیتهای ویژه روستاهای ساحلی و دریایی استان در مسیر توسعه پایدار به شمار میرود.
به گزارش ایمنا، مراسم اختتامیه همایش ملی روز روستا و عشایر روز سهشنبه با حضور مسعود پزشکیان رئیسجمهور در تهران برگزار شد.
در این مراسم رئیسجمهور و معاون وی با حضور در غرفه استان هرمزگان از نزدیک با طرحها و ایدههای برتر کارآفرینان روستایی این استان آشنا شدند.
در این بازدید، پزشکیان ضمن گفت وگو با نمایندگان استان هرمزگان در این همایش از خلاقیت جوانان و کارآفرینان روستایی استان قدردانی و بر حمایت دولت از طرحهای اقتصاد دریامحور و مشارکتهای مردمی تاکید کرد.
منبع: ایرنا

نظر شما